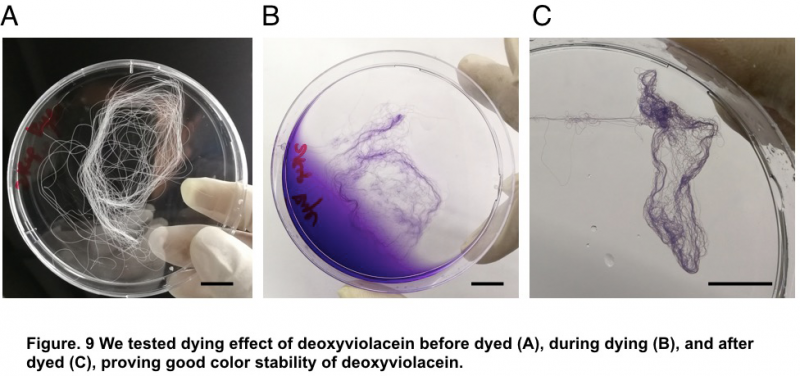
8.png

9月16日-24日,我国迎来第20届全国科普日活动,主题为提升全民科学素质,助力科技自立自强。习近平总书记关于科技创新和科学普及重要论述中指出“要在教育‘双减’中做好科学教育加法,激发青少年好奇心、想象力、探求欲,培育具备科学家潜质、愿意献身科学研究事业的青少年群体。”
少年强则科技强,科技强则中国强。激发青少年科学兴趣,培养科技后备人才,正是新哲文院科创教育的宗旨。
深实验国际教育基地
软硬件全面建设构建科创环境
党的十八大以来,国家屡次提及创新人才培养的话题;党的二十大则重申了教育创新、科教兴国的关键命题;《全民科学素质行动规划纲要(2021—2035年)》提升行动中也提到“实施科技创新后备人才培育计划”……
作为深圳实验学校国际教育基地,新哲文院继承发扬深实验科创优良传统,借助国际化办学优势,积极打造创新STEAM教育实验基地,坚定走科创办学特色,创造性将科创与国际教育相结合,长期致力于拔尖创新人才早期培养,积极向世界输送科创预备役人才。

深圳实验学校国际教育基地授牌仪式
办学13年来,新哲文院通过软硬件的全面建设,构建了科创环境和科创文化。
硬件上,为满足学生的课程需求,新哲文院积极引进多类型先进设备,打造了与国内外**竞赛接轨的**科学实验室,被誉为“最炫酷的科学实验室”。

最炫酷的科学实验室圳
按照计算机与工程、生物学、社会科学三大学科和功能,科学实验室现设置了十余个专业实验室,如分子生物实验室、FRC准工业级机器人训练基地、嵌入式工程实验室、个人项目实验室等。


新哲实验室现有设备
多台电子三目显微镜
多台体式电子三目显微镜
2个超净工作台
4个通风橱
2套凝胶电泳仪器
2套紫外凝胶分析仪
1台PCR仪
1台高压灭菌锅
1台高温烘箱
1台高速低温离心机以及多型号配套转子
1台离心式抽滤泵
2台气密式摇床
3台分光光度计
5台千分之一精度分析天平
5台实验天平
15台大功率紫外灭菌灯
25套树莓派教学主机
14个重型工作台及配套台钳
1台激光切割机
4台3D打印机
1台CAC/激光雕刻机
2套十机编队的教学无人机群
各类加工用的电锯、重型设备
5台机甲大师比赛机器人平台
机甲大师全真场地
VEX2023-24赛季OVER UNDER场地
多台往期比赛机器人
各位往期学生专利配套学生作品实物展品
4展柜生物标本
4展柜常用机械结构教学模型
2个专用的机器人工坊

我校分子生物实验室孕育了国内**在工匠收获蚁体内提取出短状杆菌Brachybacterium的实验项目,项目实验人吴逸扬同学为我校2022届毕业生,现就读于加州大学伯克利分校。
软件上,新哲文院广纳名师,由副校长彭禹领衔海内外硕博建设科创中心导师团队,打造“融合式”科技创新研究型课程,旨在让创客领域从“小众”变“大众”,让每个学生足不出校就能接受专业、高端的科技创新教育,激发内在潜质,提升综合素养。

彭禹副校长曾任上海交通大学附中科创活动中心创始人、国际科学与工程大奖赛总决赛裁判、上海市教委课程标准编写组专家、教育部课程与教材发展中心“STEAM教育推进工作”组专家、亚太青少年科学家大会特邀观察员、英特尔国际科学与工程大奖赛(ISEF)大奖裁判等,培养了大批美国前十及牛剑等世界名校毕业生,并摘得多项国际大赛桂冠,被亲切的学生们称为“科创大神”。
以实验室和科创中心为载体,学校开设了一整套计算机课程,包含Scratch入门》、《Python入门》、《爬虫与网络安全技术》等,为学生的创新发展提供了全面的课程基础;十多门科技创新社团课程,包含生物社、航空研究社、应用算法社、科学社、AMC社、FRC社等,为学生的拔高发展提供了有侧重点的课程支持;每年定期举办科技节、科普讲座等活动,实现科技教育活动与课程、实践活动相结合。
正是在软硬件的共同支持下,“科创教育”校园名片得以擦亮,并荣获“值得信赖的国际教育品牌”等称号。
亮相国内外各类科创大赛并频结硕果
为科创“苗子”搭建成长阶梯
在“科创教育”的理念指导下,新哲文院已初步探索出科技创新人才培养实施体系,13年来,百余名学生参与到科普创新的活动中来,成为社会培养创新人才预备役,同时为科创“苗子”搭建成长阶梯。
据不完全统计,2019年以来,新哲学子在创客类赛事上,共荣获6个国际金奖及超级金奖及一等奖、多个二等奖;3个“明天小小科学家”奖、12个全国一等奖及多个二三等奖、6个省市一等奖及多个二三等奖,包含CTB全球创新研究大挑战、iGEM国际基因工程大奖赛、全国青少年科技创新大赛、广东省少年儿童发明赛、华为云人工智能竞赛、FRC机器人东莞赛等,贡献出诸如“蜘蛛侠战衣”“灭霸手套”、“蚂人”“格斗机器人”等优质发明;此外,我校学生频频亮相于含金量高的国内外学术竞赛,获奖项800+人次。
“蜘蛛侠战衣”:让蜘蛛吐出彩色的蛛丝
2019年国际基因工程机器大赛(iGEM2019),我校刘雅瑄、连筱雨、胡瑞、汤思宇等同学与他们的队友一道组成的GreatBay SZ联合战队,凭借他们的“蜘蛛侠战衣”(彩色蛛丝蛋白)项目,摘取2019年国际基因工程机器大赛(iGEM2019)全球高中组**名暨世界**。
新哲文院浓郁的科创氛围和**的科研设备不仅吸引了一批批热爱科研的学生,更通过项目化的实践和学习,把学生们培养成一批批具备科创精神和实践能力的学生,从而步入世界**大学——卡内基梅隆大学、康奈尔大学、加州大学伯克利分校、埃默里大学等世界**的研究型大学均有新哲学子的身影。

今天的教育,就是明天的科技、后天的经济、未来的生产力。开展科普教育、职业启蒙教育、提升全民科学素质,助力科技自立自强,新哲文院一直行动。